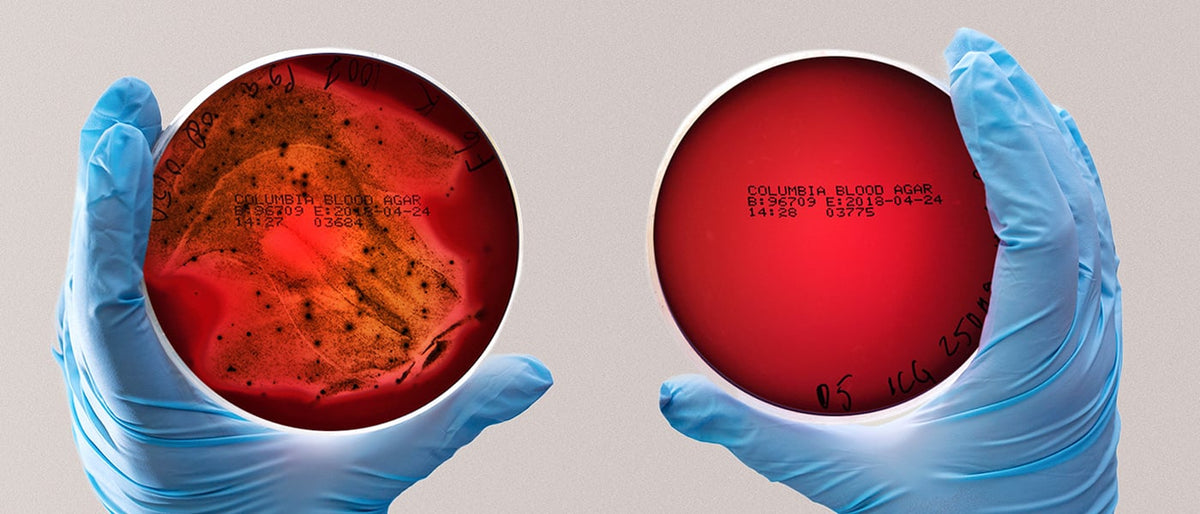

Vores Historie
I 2016 opererede hjertekirurg Tommi Pätilä en alvorlig hjerteinfektion på Helsinki Universitetshospital (HUS) i Finland. Det viste sig, at årsagen til problemerne var bakterier, der stammede fra munden. Pätilä havde en stærk følelse: noget skulle gøres. Han ønskede aldrig mere at skulle operere et hjerte, der led af mundbakterier.

Et væsentligt møde
Omkring samme tid mødte Pätilä Sakari Nikinmaa, en ingeniør, der deltog i et biodesignprojekt på børnehospitalet i Helsinki. Han ledte efter et interessant nyt projekt at arbejde på. Sammen med Nikinmaa og Biodesign-teamet besluttede de at gå efter det. De oprettede en forskergruppe på Aalto Universitet. Omfattende tekniske og antibakterielle undersøgelser begyndte.

En hjertekirurgs mission
Plakbakterier er ansvarlige for at forårsage 95% af tandsygdomme. En tandbørste er et effektivt værktøj til at bekæmpe plak. Alligevel fjerner selv den bedste tandbørste kun 65 % af plak. Pätilä var fast besluttet på at finde en løsning - der skulle gøres noget ved den resterende plak.

Grundlæggerteamet
Gruppen samlede nogle af verdens førende eksperter inden for fysik, kemi og tandlægevidenskab. De bedste teknologiske specialister blev også inddraget. Juha Rantala, en fremtrædende kemiker med speciale i halvledere og bosat i Asien, sluttede sig til gruppen. Rantala har omfattende erfaring med anvendelse af antibakterielt blåt lys. Saija Perovuo, laborant ved Afdelingen for Mund- og Kæbekirurgi, bidrog med uvurderlig viden, som var afgørende for udviklingen af Lumoral®.

Innovationen
Omfattende forsøg viste, at aktiveret fotodynamisk terapi (aPDT) alene ikke er tilstrækkelig og skal understøttes af antibakterielt blåt lys. Rantala designede og implementerede omhyggeligt LED-komponenter, der kunne udsende to forskellige bølgelængder, hvilket gjorde det muligt for teamet at komme videre. Efter tusindvis af tests blev parametrene optimeret, og den endelige metode blev udviklet som Lumoral®, med Harri Koskinen ansvarlig for designet.
Kliniske forsøg begynder
Under ledelse af professor Timo Sorsa blev der iværksat omfattende kliniske studier over hele Europa. Resultaterne viste, at Lumoral® var enestående i sin effektivitet. I randomiserede forsøg demonstrerede regelmæssig inaktivering af biofilm en betydelig forbedring i behandlingen af parodontitis, en alvorlig tandkødsinfektion. Traditionelt har parodontitis været en udfordrende tilstand at behandle, og denne nyopdagede tilgang repræsenterer et markant gennembrud inden for tandpleje.
International succes
Lumoral® har vækket betydelig international opmærksomhed. Mens karies er den mest udbredte sygdom globalt, og betændelse i tændernes støttevæv er den sjette mest almindelige sygdom, står det medicinske samfund overfor en konstant udfordring med at finde effektive løsninger til at bekæmpe disse infektioner.
Lumoral®-behandlingen har vist sig at have stort potentiale for at gavne forskellige patientgrupper, især dem med svært behandlede tilstande. Forskningsholdet fortsætter med sine videnskabelige undersøgelser gennem igangværende studier i akademiske miljøer over hele verden.
